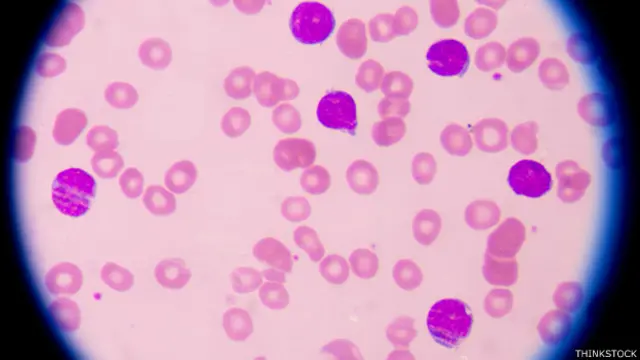
Células cancerosas

Lo que se sabe de la prometedora terapia contra el cáncer que logró remisión en hasta un 94% de casos

Fuente de la imagen, NIAID
- Autor, Redacción
- Título del autor, BBC Mundo
"Esto es extraordinario. Es algo que no tiene precedentes en medicina".
El científico estadounidense Stanley Riddell describió así los resultados de una terapia que podría revolucionar el tratamiento del cáncer en el futuro.
Utilizando las propias células del sistema inmunológico de pacientes con cáncer en estado terminal, Riddell y sus colegas lograron, en uno de sus estudios, que los síntomas de la enfermedad desaparecieran en el 94% de los casos.
Pero el propio Riddell advirtió que se trata de un estudio reducido y que existe el riesgo de efectos secundarios.
En BBC Mundo le explicamos en qué consiste la nueva terapia, por qué ha generado tantas expectativas y cuáles son sus limitaciones.
¿Por qué se habla de una terapia revolucionaria?
Riddell presentó sus estudios en la reunión anual de la Asociación Estadounidense para al Avance de la Ciencia, AAAS por sus siglas en inglés, que tiene lugar en Washington.

Fuente de la imagen, FRED HUTCHINSON CANCER RESEARCH CENTER
Los resultados del trabajo del científico, del Centro Fred Hutchinson de Investigaciones sobre el Cáncer en Seattle, recién serán publicados en detalle en los próximos meses.
Todos los estudios involucraron a pacientes con diferentes tipos de cáncer en la sangre en estado avanzado.
En el estudio más prometedor, de 35 pacientes con leucemia linfoide aguda (ALL por sus siglas en inglés), 94% entró en remisión.
En otras palabras, los síntomas desaparecieron, lo que no significa que los pacientes estén curados.
En un segundo estudio con más de 40 pacientes de linfoma, el 50% logró remisión.
Y en un grupo de pacientes con linfoma no hodgkiniano, el 80% respondió al tratamiento, presentando una reducción de síntomas.
"Estamos hablando de enfermos en los que ya no funcionaba ningún tratamiento. La mayoría de nuestros pacientes tenían expectativas de vida de entre dos y cinco meses", dijo Riddell.
¿En qué consiste la terapia?

Fuente de la imagen, THINKSTOCK
El tratamiento modifica mediante ingeniería genética a células del sistema inmunológico llamadas linfocitos T o células T que coordinan la respuesta inmune celular.
Los científicos extrajeron estas células de los pacientes y les adjuntaron moléculas receptoras que reconocen como blanco un tipo específico de cáncer. Las células modificadas fueron luego reintroducidas en el paciente.
Las moléculas se denominan receptores de antígenos quiméricos, chimeric antigen receptors o CARs por sus siglas en inglés, y reducen la capacidad del cáncer de defenderse del sistema inmunológico.
Las células cancerosas tienen mecanismos ingeniosos para ocultarse de los linfocitos o pueden abrumar por completo al sistema inmunológico.
"Esencialmente lo que hace esta técnica es reprogramar genéticamente a las células T para buscar, reconocer y destruir las células cancerosas", dijo Riddell a la BBC.
¿Puede haber efectos secundarios graves?
El principal problema del estudio ha sido el riesgo de un serio efecto secundario asociado con una respuesta inmune excesiva.
Veinte pacientes desarrollaron síntomas de fiebre, hipotensión, náuseas y neurotoxicidad asociados a la llamada tormenta de citosinas, cytokine release syndrome, sCRS por sus siglas en inglés, una reacción inmunológica defensiva potencialmente mortal.
Siete pacientes requirieron hospitalización en la unidad de cuidados intensivos y dos murieron.
¿Qué otras limitaciones tiene la terapia?
El propio Riddell advirtió que "hay razones para ser optimistas y razones para ser pesimistas".
Uno de los próximos pasos será realizar nuevos estudios con dosis más reducidas de linfocitos T modificados para evitar el riesgo de efectos secundarios.
Fuente de la imagen, THINKSTOCK
También advirtió que aún no está claro durante cuánto tiempo los pacientes seguirán en remisión.
"Aún tenemos un largo camino por recorrer. El cáncer ha vuelto a aparecer en algunos pacientes, pero los datos que tenemos hasta ahora no tienen precedentes", dijo Riddell.
Los estudios se han limitado además a cánceres en la sangre y el científico espera ahora probar la terapia en pacientes con tumores sólidos, como el cáncer de mama.
Alan Worsley, investigador del centro británico Cancer Research UK, describió la terapia como "un primer paso".
"Este tratamiento parece prometedor en algunos tipos de cáncer sanguíneo. Pero el verdadero desafío será que funcione en otros tipos de cáncer", dijo Worsley a la BBC.
Sin embargo, los estudios apuntan a un cambio de paradigma en la lucha contra el cáncer, según Riddell.
Para el investigador de Seattle, "la inmunoterapia finalmente es un pilar de la terapia del cáncer. Al igual que la quimioterapia y la radioterapia, no será una cura para todos los casos, sino que acabará siendo aplicada en ciertos tipos de tumores de ciertos tipos de pacientes".









